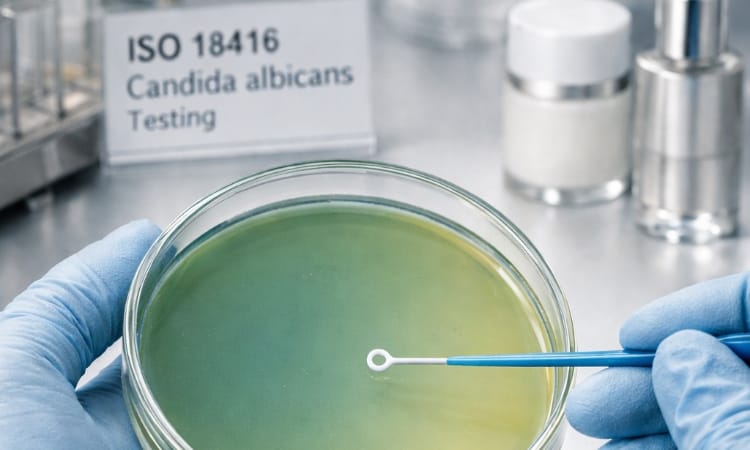
الكشف عن مادة Candida albicans في مستحضرات التجميل

الكشف عن مادة Candida albicans في مستحضرات التجميل
ISO 18416 – تحليل وجود المبيضات البيضاء (Candida albicans) في مستحضرات التجميل

لا تُعد السلامة الميكروبيولوجية في مستحضرات التجميل مجرد متطلب قانوني بموجب اللوائح التركية الحالية فحسب، بل تقع أيضًا ضمن مسؤولية الشركة المصنعة بشكل مباشر. فوجود الكائنات الحية الدقيقة المسببة للأمراض في المنتجات المستخدمة على المناطق الحساسة مثل الجلد والشفاه ومنطقة العين يمكن أن يشكل مخاطر جسيمة على صحة المستهلك.
وفي هذا السياق، يُعد معيار ISO 18416 طريقة اختبار معترف بها دوليًا ومطبقة على نطاق واسع في تركيا للكشف عن وجود المبيضات البيضاء (Candida albicans) في مستحضرات التجميل.
ما هو ISO 18416؟
ISO 18416 هو معيار تحليل ميكروبيولوجي يهدف إلى الكشف النوعي (وجود/غياب) عن المبيضات البيضاء، وهي فطر خميري قد يشكل خطرًا على صحة الإنسان في منتجات التجميل.
يعد هذا التحليل معيارًا رئيسيًا في تقييم ما إذا كانت المنتجات آمنة ميكروبيولوجيًا.
لماذا يتم البحث عن المبيضات البيضاء في مستحضرات التجميل؟
- المبيضات البيضاء هي ممرض انتهازي يمكن أن يسبب التهابات في الجلد والأغشية المخاطية
- ويمكن أن تتكاثر بسرعة في مستحضرات التجميل الرطبة وذات المحتوى الغذائي العالي
- ويعد الكشف عنها ذا أهمية حاسمة في مستحضرات التجميل للأطفال، ومنتجات منطقة العين، ومنتجات العناية الشخصية
- وتستلزم سلامة المنتج، ولوائح وزارة الصحة، وسمعة العلامة التجارية، وصحة المستهلك إجراء الاختبار.
خطوات تطبيق اختبار ISO 18416
وفقًا لمعيار ISO 18416، تتكون عملية الاختبار عمومًا من الخطوات التالية:
- تحضير العينة في ظل الظروف المناسبة وتلقيحها على وسط الاستزراع
- التحضين للتخصيب
- مراقبة نمو المستعمرات عن طريق نقلها إلى أوساط فطرية انتقائية
- تأكيد المستعمرات النموذجية لـ Candida albicans باستخدام طرق كيميائية حيوية
- الإبلاغ عن النتائج على أنها ”موجودة“ أو ”غير موجودة“
ما هي منتجات التجميل التي يتم اختبارها باستخدام اختبار ISO 18416؟
- منتجات العناية بالبشرة (الكريمات والمستحضرات والسيروم)
- الشامبو وجل الاستحمام
- مستحضرات العناية بالعيون
- مرطبات الشفاه وأحمر الشفاه
- مستحضرات تجميل الأطفال
- منتجات النظافة ومستحضرات التجميل الجلدية
أهمية تحليل ISO 18416
- يضمن الجودة الميكروبيولوجية لمنتجات التجميل
- يتوافق مع لوائح مستحضرات التجميل التركية ولائحة مستحضرات التجميل للاتحاد الأوروبي (1223/2009/EC)
- يدعم متطلبات ISO 22716 GMP لمستحضرات التجميل الصادرة عن المنظمة الدولية للتوحيد القياسي
- يلعب دورًا حاسمًا في تقييمات السلامة التي تُجرى قبل طرح المنتج في السوق
- يعزز ثقة المستهلك ويوفر ميزة للعلامات التجارية في عمليات التدقيق
ISO 18416 – خدمة تحليل Candida albicans
نجري اختبار ISO 18416 – فحص Candida albicans لمنتجات التجميل وفقًا للمعايير الوطنية والدولية باستخدام البنية التحتية لمختبراتنا المعتمدة.
نقدم خدمات تحليل سريعة وموثوقة ومتوافقة مع اللوائح التنظيمية لـ مصنعي مستحضرات التجميل والمستوردين والعلامات التجارية العاملة في جميع أنحاء تركيا.
📞 اتصل بنا للحصول على معلومات تفصيلية حول تحليل ISO 18416 وطلب عرض أسعار.
تابعنا على LinkedIn للحصول على آخر الأخبار والتحديثات حول خدماتنا.
تابع حسابنا على Instagram لتبقى على اطلاع بأحدث منشورات مدونتنا.